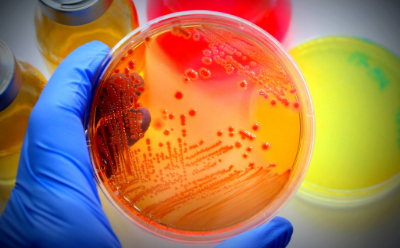
培养皿中可见细菌生长

实验室水净化
引言
实验室用水是任何实验室中最重要的试剂之一。它在配制缓冲液和培养基方面发挥着关键作用,在许多实验中用作空白对照,为临床化学分析仪和其他仪器提供水源,并用于清洁实验室设备。 选择最佳的实验室用水质量——无论是1类水(超纯水)、2类水(纯水)还是反渗透水——都是获得可靠、准确且可重复实验结果的基础。
要确保水质的一致性,首先要为您的实验室及各项应用(从分析化学到细胞与分子生物学、临床诊断等)选择合适的水净化设备。
将此“实验室用水学习中心”加入书签,以便随时获取来自Milli-Q®水处理系统研发团队科学家的专业指导。
- 获取针对您应用场景选择合适水质的建议
- 了解水污染物的影响及防范措施
- 比较实验室水净化技术,探索先进的实验室水处理系统
无论您是分析化学家、临床微生物学技术员、生物学家,还是食品饮料制造商,成功的关键都始于稳定的水纯度。
Section Overview
网络研讨会
Section Overview
登录以继续。
如要继续阅读,请登录或创建帐户。
暂无帐户?